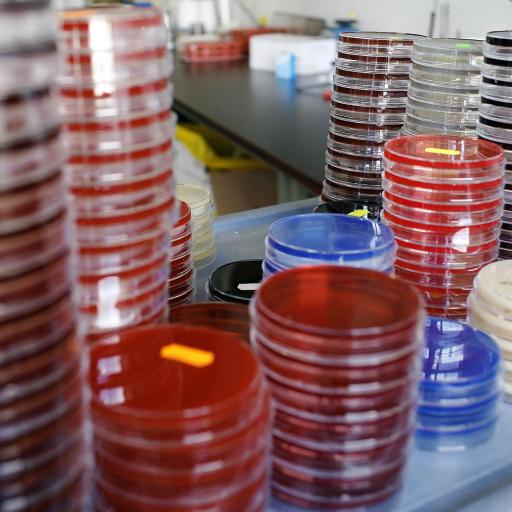

Search
Andrey Shaw
Andrey S. Shaw, an immunologist, is Staff Scientist in Immunology and Oncology at Genentech and holds adjunct professorships at Washington University in St. Louis and at the University of California, San Francisco.
Read Less